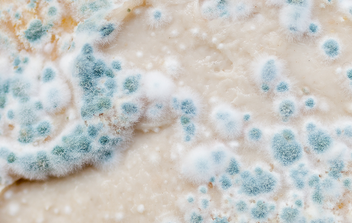
10 Science-backed Natural Remedies for Congestion - Molekule

Immerse yourself in the artistic beauty of 10 natural treatments for congestion relief | lignosus through numerous inspiring images. where technical excellence meets creative vision and artistic expression. transforming ordinary subjects into extraordinary visual experiences. Discover high-resolution 10 natural treatments for congestion relief | lignosus images optimized for various applications. Ideal for artistic projects, creative designs, digital art, and innovative visual expressions All 10 natural treatments for congestion relief | lignosus images are available in high resolution with professional-grade quality, optimized for both digital and print applications, and include comprehensive metadata for easy organization and usage. Our 10 natural treatments for congestion relief | lignosus collection inspires creativity through unique compositions and artistic perspectives. The 10 natural treatments for congestion relief | lignosus archive serves professionals, educators, and creatives across diverse industries. Cost-effective licensing makes professional 10 natural treatments for congestion relief | lignosus photography accessible to all budgets. Advanced search capabilities make finding the perfect 10 natural treatments for congestion relief | lignosus image effortless and efficient. Diverse style options within the 10 natural treatments for congestion relief | lignosus collection suit various aesthetic preferences. Time-saving browsing features help users locate ideal 10 natural treatments for congestion relief | lignosus images quickly. Instant download capabilities enable immediate access to chosen 10 natural treatments for congestion relief | lignosus images.